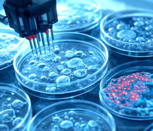

Pour avoir un rendu optimal, mettez votre affichage à 100 % (Ctrl + 0).
Interview p. 8
Kenza, étudiante en DEUST Préparateur en pharmacie
BTS MECP : la beauté en formation
Pages 4 et 5
Vie du lycée p. 2
Bureau des étudiants : faire vivre le campus !

| N° 29 - Février 2026 | www.lyceejdarc.org |
Culture p.10
« Stranger Things », clap de fin sur une série mythique
Les TCCSHCR, à votre service !
Le Père Golfier, prêtre au Havre de la paroisse Saint-Étienne-des-Hautes-Terres, nous a proposé d'organiser et de servir le vendredi 16 janvier 2026 lors des vœux et de l'inauguration de la salle qui s'appelle désormais "Centre paroissial Gaston Raoult", ancien résistant havrais béatifié. Nous étions encadrés par nos professeurs d'enseignement professionnel et de français, Kristell Radigois et Hélène Taberlet. Retour en détail sur cette soirée.
La préparation du service
Nous avons tout d'abord déterminé le nombre de pièces pour un service de 70 personnes. Nous avons ensuite calculé le coût de revient par personne puis nous avons sélectionné les pièces sur catalogue. Avec ces éléments, nous nous sommes rendus à Promocash, un grossiste spécialisé dans la restauration, pour récupérer notre commande.
La mise en place
À 17h, nous sommes arrivés au centre paroissial de l'église Saint-Denis de Sanvic. Un groupe s'est occupé d'installer la salle tandis que l'autre préparait les plateaux de mises en bouche. Puis, nous nous sommes tous retrouvés dans l'office pour le briefing destiné au service. Vers 18h30, les convives sont arrivés.
La soirée a débuté par le discours du Père Golfier et diverses interventions pour présenter Gaston Raoult. Pendant ce temps, nous nous entraînions à ouvrir les bouteilles de cidre de manière professionnelle, à savoir le plus silencieusement possible.
Le coup de feu
Une fois les discours terminés, la brigade s'est divisée en deux parties : certains étaient barmen, d'autres proposaient en salle les canapés disposés sur les plateaux. Au fur et à mesure du service, les postes ont évolué en fonction des besoins des invités.
Une expérience à revivre
Nous avons reçu un accueil très chaleureux et avons été remerciés pour la qualité de notre travail et notre efficacité. Cette expérience fut valorisante pour nous tous, à la fois pour la cohésion de la classe et l'acquisition de nouvelles compétences. Avec l'argent gagné, nous organiserons une sortie de fin d'année avec nos professeurs pour fêter la fin de nos études en CAP Commercialisation et services en Hôtel-Café-Restaurant.
Les élèves de TCCSHCR
BDE : « Créer une dynamique »
Interview - Manon Dalençon, animatrice en pastorale et fondatrice du Bureau des étudiants, et Alix Côme, étudiant en première année de BTS Tourisme.
Pourquoi avoir créé un Bureau des étudiants (BDE) ?
Manon Dalençon : Nos étudiants sont répartis sur plusieurs sites - Coty, le CFA, le Parc -, ce qui rend la cohésion difficile. Le but était de créer un BDE sur le modèle de ce qui existe à l'université ou dans d'autres écoles, pour créer une dynamique étudiante.
Alix : Cela fait vivre le campus : au moins, il se passe des choses !
Et est-ce que beaucoup d'étudiants y participent ?
Manon Dalençon : En tout, il y en a 25, dont une quinzaine très actifs.
Comment financez-vous ce projet ?
Manon Dalençon : À l’heure actuelle, nous n’avons pas de financement et toutes nos actions sont gratuites. L'objectif est de collecter des fonds en organisant des ventes.
Et comment vous trouvez-vous des idées d'activités ?
Alix : Il y a des réunions, sur Zoom ou en présentiel, durant lesquelles nous échangeons nos idées. Différents pôles se sont aussi constitués : le pôle sport, le pôle communication...
Manon Dalençon : ...et aussi le pôle écologie, le pôle culture. Et puis, le pôle partenariat. Il s'agit de démarcher des organismes, des restaurants, les bars afin d'obtenir soit des réductions, soit des partenariats.
Chacun s'inscrit dans un ou plusieurs pôles. Le but est de mutualiser les idées et de participer aux projets qui nous inspirent.
Un mot sur votre mascotte ?
Manon Dalençon : C’est une super mascotte. Un renard orange. Les étudiants doivent encore lui choisir un nom.
Propos recueillis par
Clara Dalifard, Clara Agoutin
et Manon Hébert, 2GTE
Être une fille en STI2D : « Dans les projets, c'est souvent moi qui m'incruste »
Interview
Anna, élève en 1STI2D et Manuela, élève en TSTI2D (Sciences et technologies de l'industrie et du développement durable).
Pourquoi avez-vous choisi cette filière ?
M : À la fin de ma seconde, j’ai choisi cette filière car je voulais être ingénieure en énergie renouvelable. Finalement, je pense plutôt travailler dans les télécoms.
A : Je suis entrée en STI2D pour devenir architecte mais je songe actuellement à travailler dans l’électricité, ce qui correspond davantage à ma filière.
Vous attendiez-vous à ce qu'il y ait autant de garçons dans votre classe ?
M. : Ça a été une surprise pour moi de me retrouver avec autant de garçons, nous ne sommes que deux filles dans la classe.
Les autres élèves vous mettent-ils à l’aise pour les travaux de groupe ?
M : Non, pas vraiment. Je suis souvent seule à mener les projets. Cependant, quand c’est obligatoire, certains élèves m’invitent à venir avec eux.
A : Pendant les travaux de groupe, c'est souvent moi qui m'incruste. Les garçons ne travaillent pas toujours assez, alors je les motive.
Cette situation est-elle un atout ou un handicap ?
A. : C’est plutôt un atout car il y a moins de filles, donc moins de problèmes. Même si le fait d’être la seule fille peut parfois être lourd. J’aurais aimé que nous soyons au moins deux dans la classe. Je fais avec, sachant que cette filière me plaît.
M : Cela peut être un atout comme un handicap. Le handicap, c'est qu'une fille aura peut-être du mal à se faire beaucoup d’amis et devra se faire respecter.
Quel conseil donneriez-vous à une fille qui souhaite intégrer cette filière ?
M. Restez concentrée sur votre objectif !
Propos recueillis par Margaux Lange et Alice Debieu, 2GTE
Être un garçon en ST2S : « Cela permet de dépasser les préjugés »
Interview
Naël et Borys, élèves en terminale ST2S, Dimitry, élève en première ST2S (Sciences et technologies de la santé et du social )
Pourquoi avez-vous choisi cette filière ?
Naël : J’ai choisi la filière ST2S car je veux travailler dans le social.
Dimitry : J'ai choisi cette filière pour être infirmier-sapeur-pompier.
Borys : Je me suis inscrit essentiellement pour la biologie.
Avez-vous été surpris qu'il y ait autant de filles dans votre classe ?
Naël : Je n’ai pas vraiment été surpris car j’ai toujours su que c’était une filière particulièrement féminine mais cela représente quand même un changement.
Borys : Je n'ai pas été choqué car je savais que je serais confronté à une classe de filles et dès la première, tout s'est très bien passé.
Vivez-vous cette situation comme un atout ou un handicap ?
Naël : Pour moi, c'est positif car je vais exercer un métier majoritairement féminin alors cela me prépare à la réalité.
Et puis, cela permet de dépasser les préjugés.
Dimitry : Ce n'est pas vraiment un handicap, mais certaines filles ont tendance à aller plus facilement vers leurs amies. C'est à nous, garçons, de faire l'effort de nous intégrer.
Que conseilleriez-vous à un garçon qui souhaite intégrer la filière ST2S ?
Naël : C'est sûr qu'il devra faire des efforts pour trouver sa place.
Borys : Et il faut surtout venir en ST2S par choix pour la filière et non pour les élèves qui la suivent.
Dimitry : Je lui dirais qu'il ne faut surtout pas hésiter car c'est une très bonne filière pour se préparer à certains métiers. Et au niveau ambiance de classe, on s'entend tous très bien.
Propos recueillis par
Margaux Lange
et Alice Debieu, 2GTE
Le BTS MECP : une formation complète et enrichissante
Des techniques esthétiques au commerce jusqu’à l’animation et au management, ce BTS révèle toute la richesse d’une formation aux multiples facettes.
Le BTS Métiers de l’esthétique, de la cosmétique et de la parfumerie (MECP) ne se limite pas à l’apprentissage des techniques esthétiques. Il s’agit d’une formation complète qui allie savoir-faire technique, connaissances scientifiques, compétences commerciales et qualités humaines. Les étudiants sont aussi formés à la gestion de la relation client, à la communication, au travail en équipe et à l’adaptation à différents publics.
Des environnements variés
Bien au-delà de l’image parfois réductrice de la seule beauté extérieure, le BTS MECP prépare les étudiants à devenir de véritables professionnels capables d’intervenir sur le bien-être global des personnes, en tenant compte des dimensions physique, mentale et émotionnelle.
Cette approche globale permet de former des professionnels aptes à évoluer dans des environnements variés tels que les instituts, les spas, les structures de bien-être, le secteur sportif ou encore les entreprises de cosmétique et de parfumerie.
La poursuite d'études
Après le BTS MECP à Jeanne d'Arc, les étudiants peuvent poursuivre leurs études en intégrant, par exemple, la licence professionnelle Formulation et Analyses des Produits Cosmétiques à l'université du Havre, une licence du champ de la cosmétologie ou encore une licence d’autres champs (management, commerce, etc.). Il est également possible d'obtenir la certification « Retail Manager Mode & Beauté » de l'école EMA Sup Paris.
Léana Deloeil, Roxane Courseaux et Yéléna Cosson, 1BTS MECP
Une formation ancrée dans le monde professionnel
Interventions de professionnels, conférences, projets concrets offrent aux étudiants des enseignements connectés aux réalités du terrain.
Un pilier essentiel
Au cœur de cette formation, les partenariats occupent une place essentielle. En lien avec les acteurs du secteur de la beauté, du bien-être, du sport et du luxe, ces collaborations permettent de connecter les enseignements théoriques aux réalités du terrain.
Grâce à ces partenariats, les étudiants développent des compétences variées : techniques, relationnelles, commerciales et organisationnelles. Ils apprennent à adopter une posture professionnelle adaptée, à comprendre les attentes des publics et à s’inscrire dans une démarche de qualité de service. Dans un contexte où le bien-être occupe une place croissante, le BTS MECP forme des professionnels polyvalents, capables de répondre à des besoins diversifiés, allant du soin esthétique au bien-être global.
Des actions au service du territoire
Tout au long de l’année, le BTS MECP s’implique activement dans des actions professionnelles au service du territoire havrais. En partenariat avec le Centre communal d'action sociale (CCAS) de la ville du Havre, les étudiants participent à des projets concrets visant à promouvoir le bien-être, l’estime de soi et le lien social auprès de publics variés.
La formation s’illustre également par son nouveau plateau Mary Cohr, où les étudiants interviennent dans un cadre professionnel exigeant. Cet espace permet de mettre en pratique les techniques de bien-être tout en développant rigueur, adaptabilité et posture professionnelle.
Les étudiants interviennent également tout au long de l’année au sein de différentes structures, telles que les Bains des Docks, renforçant ainsi la dimension humaine et sociale du BTS MECP. Ces actions illustrent pleinement l’approche globale de la formation, qui place le bien-être, l’écoute et l’accompagnement au cœur des pratiques professionnelles, bien au-delà de l’esthétique traditionnelle.
Léana Deloeil, Roxane Courseaux et Yéléna Cosson, 1BTS MECP
Une action gratifiante auprès du HAC
Allier bien-être, sport et accompagnement dans un contexte professionnel : telle a été la mission de trois étudiantes du BTS.
Trois étudiantes de la formation BTS MECP ont mené une action professionnelle en partenariat avec le HAC (le Havre Athletic Club), auprès de l’équipe féminine. Cette action consistait à proposer des massages bien-être adaptés aux sportives, dans un objectif de détente, de relâchement mental et de récupération physique.
D’après le témoignage de ces étudiantes, il s’agit d’une expérience « particulièrement enrichissante » au regard des compétences développées en BTS MECP. Elle leur a permis de « mettre en pratique » leurs connaissances techniques tout en « tenant compte des besoins spécifiques d’un public sportif ».
Au-delà du soin, cette action a mobilisé des compétences relationnelles essentielles telles que l’écoute, l’adaptation, le professionnalisme et le respect du cadre : « Intervenir auprès d’une équipe sportive illustre parfaitement la dimension humaine et polyvalente de ce BTS, qui forme des professionnels capables d’agir sur le bien-être global des personnes, au-delà de l’apparence », expliquent les étudiantes.
Plus qu’une action ponctuelle, ce partenariat illustre la volonté du BTS MECP de former des professionnels polyvalents, capables de s’inscrire dans des projets concrets et porteurs de sens, au croisement du bien-être, de la performance et de l’accompagnement humain.
Les étudiants du BTS MECP
L'engagement étudiant : un pilier qui place l'humain au cœur de l'action
Tout au long de leur formation, les étudiants du BTS MECP se placent dans une démarche professionnelle au contact de publics diversifiés.
Aller à la rencontre des jeunes pour témoigner
Les actions professionnelles menées au sein du BTS touchent diverses cibles : la formation est présentée auprès de différents établissements scolaires comme des lycées professionnels et technologiques normands ou d'ailleurs ou encore la mission locale qui accompagne les jeunes dans leurs projets. Le but est d’informer et d’orienter les jeunes intéressés par les métiers du BTS. Durant cette présentation, les étudiants exposent leur ressenti et le contenu de la formation, les compétences développées au cours du cursus, les débouchés professionnels ainsi que les poursuites d’études. Les étudiants peuvent également présenter leur formation lors de journées Portes ouvertes ou de forums. Les étudiants concernés ont pu ainsi développer des compétences en communication, en travail d’équipe et prise de parole.
Favoriser le lien intergénérationnel
Des moments sincères de détente, d’échange et d’écoute sont organisés avec les personnes âgées au sein de maison de retraite. Plusieurs ateliers sont proposés pour valoriser ce public qui oublie souvent l'importance du soin et de la beauté. L’objectif est de redonner de la confiance et de favoriser le lien intergénérationnel, permettant l’engagement, la bienveillance et l’apprentissage.
Les étudiants du BTS MECP

Tout savoir sur le bitcoin, la révolution monétaire numérique
Apparu en 2009, le Bitcoin bouscule les codes de la finance mondiale. Décryptage d'une cryptomonnaie qui est devenue un véritable phénomène de société.
Une monnaie numérique décentralisée
Le Bitcoin est une monnaie numérique, ce qui signifie qu’il n’existe que sur Internet et qu’il ne dépend d’aucune banque ou institution financière traditionnelle. Contrairement aux monnaies classiques, le Bitcoin fonctionne grâce à un réseau décentralisé d'ordinateurs, où des utilisateurs vérifient et valident les transactions sans passer par une banque. Ce système décentralisé garantit que le Bitcoin échappe à tout contrôle gouvernemental ou bancaire.
La Blockchain :
un gage de sécurité
Toutes les transactions sont enregistrées dans un registre public appelé Blockchain, qui assure leur transparence et leur sécurité. Cette technologie rend les échanges presque impossibles à falsifier, ce qui en fait une option très sûre pour ceux qui souhaitent effectuer des transactions. Il est possible d’acheter des bitcoins sur des plateformes comme Coinbase ou Binance, qui offrent des services de trading permettant aux utilisateurs majeurs d’acheter, de vendre ou d’échanger des cryptomonnaies.
Une rareté programmée
Contrairement aux monnaies classiques que l'on peut imprimer à l'infini, le Bitcoin est limité. Il n'y aura jamais plus de 21 millions de bitcoins. Cette rareté est ce qui lui donne sa valeur. Pour cette raison, le Bitcoin est parfois comparé à l'or, rare et limité lui aussi.
Des inconvénients à prendre en compte
Le prix des bitcoins est très volatile, ce qui peut rendre son investissement très incertain, avec un risque important de perte en capital. Cette cryptomonnaie consomme également une quantité d’énergie considérable, ce qui soulève des questions sur son impact environnemental. Par ailleurs, l’anonymat du Bitcoin peut être utilisé pour des activités illégales, bien que des efforts de régulation soient en cours pour limiter cette utilisation.
Anecdote
Si tu avais acheté pour 2000 euros en Bitcoin en 2013, cet investissement te rapporterait aujourd’hui d’environ 371 400 euros. Un rendement spectaculaire qui reste exceptionnel et donc difficilement reproductible.
Mathéo Monnier, 2GTE
The Bitcoin Society : utopie ou révolution ?
Le 24 novembre 2025, l’entrepreneur français Éric Larchevêque a dévoilé à Paris son nouveau projet qui pourrait révolutionner le monde de l'entrepreneuriat.
La présentation s’est tenue à l’Espace Clacquesin, à Malakoff, au sud de Paris, devant près de 500 invités soigneusement sélectionnés, parmi lesquels figurait Tony Parker, ancienne star du basket français. L’ambition affichée est claire : proposer une révolution du modèle économique et entrepreneurial, à contre-courant du système actuel.
Un système monétaire remis en cause
Selon Éric Larchevêque, le système monétaire mondial repose aujourd’hui sur la dette et montre ses limites. L'entrepreneur appelle à une alternative plus adaptée aux enjeux contemporains : une monnaie stable, indépendante des États et des banques centrales, et dont la quantité serait contrôlée par des algorithmes. Cette monnaie existe déjà, affirme-t-il : c'est le bitcoin. Mais elle serait encore largement sous-utilisée. Son objectif est donc de faire du bitcoin un nouvel étalon monétaire mondial, capable de s’intégrer au système financier classique avant, peut-être, de s’y imposer.
Entreprendre autrement
Cependant, une nouvelle monnaie ne suffit pas à transformer la société. Pour Éric Larchevêque, le véritable moteur du changement doit venir des entrepreneurs, ceux qui créent de la valeur, et non de l’État. Il critique notamment le modèle français, où le travail et la prise de risque sont fortement taxés. Son projet repose sur une idée centrale : placer la liberté d’entreprendre au cœur du système, en s’appuyant sur le bitcoin. L’objectif est de fédérer des créateurs, investisseurs et épargnants partageant les mêmes valeurs, afin de constituer une force collective capable de dialoguer avec les grandes institutions internationales.
Un projet structuré autour de trois piliers
Pour concrétiser cette vision, Éric Larchevêque et ses associés ont lancé une OPA (Offre publique d'achat) sur Tayninh, une entreprise cotée en bourse mais en sommeil. Elle sera réorganisée autour de trois axes principaux :
- Bitcoin Treasury Company : la création d’une réserve stratégique de bitcoins sur le long terme, ouverte à de nouveaux actionnaires.
- Network Society : un réseau destiné à rassembler et défendre les entrepreneurs favorables à cette vision.
- Club Premium : un espace réservé aux épargnants et aux entrepreneurs impliqués dans le projet.
Sous les applaudissements du public, Éric Larchevêque a officiellement dévoilé le nom de cette initiative : The Bitcoin Society. Reste à savoir si ce projet marquera durablement le monde de l’entrepreneuriat ou s’il restera une ambition de plus dans l’univers très mouvant des cryptomonnaies. L’avenir le dira.
Tom Poret
et Jules Durecu, 2GTE
« Témoigner pour ne jamais oublier »
Interview : Henriette Leprovost, 98 ans, survivante des bombardements du Havre.
Quel âge aviez-vous quand la guerre a commencé ?
C’était en 1939, j’avais 12 ans. Je ne comprenais pas que la guerre avait commencé. Ce sont mes parents qui me l'ont expliqué.
Que s'est-il alors passé ?
En 40, on a été évacué, avec mes petits frères de 3 et 4 ans, à Espelettes, près de Biarritz. Nous y sommes restés deux mois avant d’être rapatriés au Havre où nous avons subi les premiers bombardements, pas trop sévères au départ.
Comment vous êtes-vous engagée dans les équipes nationales ?
C’est au collège, en 1943, qu’Henriette Pelse, la cheftaine des équipes nationales, est venue nous expliquer le rôle des jeunes qu’ils cherchaient à recruter. C’est ainsi que je me suis enrôlée dans les Équipes nationales, des groupes de jeunes qui aidaient les civils et sauveteurs comme la Croix-Rouge ou la Défense passive à déblayer des maisons pour trouver des survivants. Lorsqu’il y avait des bombardements, on allait secourir les personnes et aider les sinistrés à déménager. Quand Rouen a subi un bombardement en avril 44, nous y sommes allés pour apporter notre aide, pendant une semaine. Et puis la vie a continué comme ça jusqu’au 5 septembre.
Que s’est-il passé, le 5 septembre ?
Quand Le Havre a été bombardé, je me trouvais dans l'immeuble Guillaume Tell, qui était le QG des équipes, à l’emplacement de l'actuel Bistrot parisien. On s'est réfugiés dans la cave et j’ai été ensevelie pendant plus de deux heures, tout a été rasé au-dessus de nos têtes. Mais j’en suis sortie. A ma connaissance, nous ne sommes plus que deux équipières encore en vie. Je témoigne le plus possible pour faire perdurer la mémoire de cette période et de ces équipiers qui étaient des gens dévoués.
Quel a été le moment le plus marquant pour vous ?
Le 5 juin 44, la veille du débarquement, un avion de reconnaissance a lâché une bombe qui a frappé la maison de mes parents. Mon père, ma mère et ma sœur aînée ont été tués. Après cet événement, c’est ma tante qui m’a recueillie.
Et la libération du Havre ?
Je ne l’ai pas trop vécue parce que lorsque on a été enseveli, on a respiré énormément de saletés, ce qui m'a rendue très malade. J’ai été soignée dans le tunnel Jenner par des Allemands parce qu’il n'y avait plus de place dans l’hôpital français. Là, j’ai eu très peur car le commandant de la place ne voulait pas se rendre. Je craignais qu’il me prenne en otage ou qu’il me tue.
Craignez-vous une nouvelle guerre ?
Quand j’ai entendu la déclaration de guerre de Poutine à l’Ukraine, j’en aurais pleuré. On ne va quand même pas faire une 3ème guerre mondiale ! A Gaza, je les entends sans arrêt signer des accords de paix, mais ils continuent de se taper dessus. Je ne souhaite à personne de connaître une guerre.
Propos recueillis par
Amélie Doublemart, 2GTB
« Parler, ce n'est pas un signe de faiblesse »
Au lycée, il arrive à tout le monde de traverser des moments compliqués. Pour ne pas rester seul face à ces difficultés, le Point Écoute, animé par Guillaume Avenel, est là.
Interview
Guillaume Avenel, animateur du Point Écoute au lycée, formateur et secouriste santé mentale.
Pouvez-vous présenter le Point Écoute ?
Au lycée, il arrive à tout le monde de traverser des moments compliqués. Pour ne pas laisser un jeune face à ces difficultés, le Point Écoute est là. Il s'agit d'un lieu neutre et confidentiel pour parler librement, où les lycéens peuvent venir discuter de ce qui les préoccupe. Le Point Écoute est un espace d’aide et de soutien pour tous les lycéens qui en ressentent le besoin. Mon rôle est d'écouter sans juger, d'aider à mieux comprendre les situations et de chercher des solutions à leurs différents problèmes, en toute bienveillance.
Pourquoi venir au Point Écoute ?
Les lycéens peuvent venir au Point Écoute pour de nombreuses raisons : stress, problèmes familiaux, difficultés alimentaires, manque de confiance en soi, etc. La parole est libre et tout ce qui est dit reste confidentiel, sauf en cas de danger grave.
Quelles solutions sont proposées ?
Au Point Écoute, on apporte avant tout des conseils concrets. Nous pouvons par exemple apprendre à mieux communiquer grâce à un contrat de communication (ce que je veux, ce que je refuse, ce qui est négociable). Pour le stress et l'anxiété, des explications simples permettent de comprendre ce qui se passe dans le corps et de trouver des solutions pratiques. En cas de manque de confiance en soi, les échanges aident à changer le regard que l'on porte sur soi-même et à mettre en place des actions positives. Le message important est de dire que parler, ce n'est pas un signe de faiblesse.
Quand et comment peut-on se rendre au Point Écoute ?
Sur le site de Gaulle, le Point Écoute est ouvert mercredi et jeudi matin, de 8h à 12h. Sur le site Coty, il est ouvert les jeudis après-midi de 13h30 à 17h30. Une permanence est assurée une fois par mois de 8h à 17h30. Les rendez-vous sont à prendre auprès de l'infirmière scolaire de chaque site.
Propos recueillis par
Kalyssa Devaux, TCPSR
La reproduction cellulaire au service des grands brûlés
Suite à l'incendie d'un bar de la station suisse Crans-Montana le 1er janvier 2026, de nombreux rescapés présentent des brûlures graves sur l’ensemble de leur corps. Ces blessures soulèvent des questions quant aux traitements administrés. Comment les biotechnologies peuvent-elles aider ces grands brûlés à se reconstruire ?
Reconstruire la peau grâce à la culture cellulaire
Parmi les traitements biotechnologiques existants, la culture cellulaire occupe une place essentielle, notamment dans les cas les plus extrêmes. Cette technique consiste à prélever une petite surface de peau saine chez le patient - environ 10 cm² - puis à cultiver ses cellules en laboratoire.
Grâce à ce procédé, il est possible d’obtenir une surface de peau assez grande pour recouvrir des zones étendues, comme le dos. Les premiers développements cellulaires apparaissent après environ trois semaines, tandis qu’il faut compter cinq à six semaines pour obtenir une culture complète mêlant épiderme et derme. Ce temps de culture reste long : en moyenne, une cinquantaine de plaques de peau de 10 cm² sont nécessaires pour débuter la reconstruction. Une fois prêts, les greffons sont transplantés sur le patient par le chirurgien.
La réduction du rejet
L’un des atouts de cette méthode réside dans le fait que la peau greffée provient du patient lui-même. Cette auto-greffe limite ainsi le risque de rejet immunitaire, un enjeu crucial dans la prise en charge des grands brûlés.
Des technologies complémentaires en plein essor
D'autres technologies innovantes voient le jour. Parmi elles, la bio-impression 3D de cellules à l’aide d’une encre cytocompatible permet de remplacer le derme manquant après la première opération.
Une autre méthode repose sur l’utilisation de pansements enrichis en hémoglobine de vers marins, contenant notamment la molécule M101, associée à de l’acide hyaluronique. Ce type de pansement favorise l’hydratation des tissus et accélère la cicatrisation. Bien que prometteuse, cette approche ne remplace cependant pas les greffes de peau. En Suisse romande, les spécialistes des grands brûlés suivent attentivement les avancées liées à cette méthode, sans l’appliquer systématiquement à ce jour.
Conclusion
La prise en charge des brûlures étendues repose aujourd’hui principalement sur l’auto-greffe et la culture cellulaire, des techniques indispensables pour reconstruire la peau et limiter les risques de complications. Toutefois, les innovations en biotechnologie ouvrent des perspectives prometteuses et laissent espérer des traitements toujours plus efficaces et adaptés aux patients.
Télio Grancher, Hanaë Thibault, Mathis Lefrique,
Lucas Alix Delorme (TSTL)
« L'alternance était un critère essentiel »
Interview - Kenza Arid, étudiante en alternance en DEUST Préparateur en pharmacie.
Pourriez-vous nous présenter votre formation ?
Je suis en 1ère année de Diplôme d'études universitaires scientifiques et techniques (DEUST) Préparateur / technicien en pharmacie. C'est une formation sur deux ans qui s'effectue en alternance. Ainsi, chaque semaine, je travaille deux jours au CFA Jeanne d’Arc et trois jours dans la pharmacie d'Yport.
Quel bac avez-vous passé ?
Un bac STL au lycée Jeanne d'Arc, qui m’est très utile pour certaines notions d’anatomie et de chimie.
Qu’est-ce qui vous a motivée pour choisir cette formation ?
Je n’aurais pas supporté d’être en présentiel toute la semaine alors l’alternance était un critère essentiel. Et je voulais travailler dans le secteur de la santé : la pharmacie était ce qui se rapprochait le plus de mon bac.
Dans le cadre de votre alternance, êtes-vous rémunérée ?
Oui, je suis rémunérée. Cela fait aussi partie des avantages de l’alternance.
Avez-vous rencontré des difficultés pour trouver votre employeur ?
Oh, oui ! J’ai dû postuler dans une centaine de pharmacies avant de trouver mon employeur actuel.
Combien d’heures de travail effectuez-vous chaque semaine ?
35 heures, dont 22 en pharmacie.
Est-ce difficile de concilier la formation et le travail ?
Pour moi, il est plus compliqué de réviser les cours que d’être en pharmacie, car je suis une personne qui préfère la pratique à la théorie. Mais je suis très motivée à l’idée de devenir préparatrice en pharmacie, alors ça va aller.
Vous préférez donc la partie en entreprise ?
Largement ! En plus, j’ai une patronne formidable et des collègues géniaux.
Recommanderiez-vous cette formation à d’autres personnes ?
Le DEUST pharmacie est une très bonne voie pour quelqu’un qui veut travailler rapidement dans le milieu pharmaceutique et qui ne se projette pas dans des études trop longues. Il faut aimer le contact avec les patients et apprécier l’alternance entre les études, qui nécessitent un véritable investissement, et le travail en pharmacie. En revanche, pour quelqu’un qui veut devenir pharmacien ou faire de la recherche, il faudra plutôt viser des études longues en pharmacie.
Propos recueillis par
Thibaut Cantais, 2GTE
« Être Miss m'a donné confiance en moi »
Interview
Naomie Renaud, 19 ans, étudiante en deuxième année de BTS Tourisme a été candidate au concours Miss Le Havre 2026.
À quel âge avez-vous commencé les concours de Miss ?
Vers l'âge de 15 ans. J'ai participé à des petits concours de campagne, puis à l'échelle de la ville et de la région.
Y a-t-il des critères précis pour y participer ?
Pour ceux que j'ai pu faire, non. C'est vraiment très inclusif. Pour le concours Miss France, par contre, il existe une taille réglementaire. Le poids, lui, n'est théoriquement pas réglementé, mais on se rend compte que toutes les candidates ont la même morphologie.
Qu'est-ce qui vous a motivée ?
C'est vraiment grâce à ma maman. Mais c'est aussi un rêve de petite fille. Et comme j'aime beaucoup la mode, la danse et monter sur scène, ça a été une évidence. L'élément déclencheur a été un shooting photo organisé par mes parents. Après avoir vu le résultat, je me suis dit : « Ah, j'aime vraiment bien faire ça ! »
Avez-vous déjà gagné des titres ?
J'ai eu la chance de gagner un titre de deuxième dauphine de Miss Pays de l'Austreberthe. Mais le plus haut titre que j'ai gagné, c'est Miss Teen Belleza Normandie en 2025, qui m'a permis de représenter la Normandie au niveau national. Ce fut une expérience très enrichissante pour dépasser mes limites.
Voudriez-vous devenir Miss France ?
Malheureusement, je n'ai pas la taille requise : il faut mesurer au moins 1m70 et je mesure 1m63.
Que faites-vous lors de ces concours ? Des défilés, des danses ?
La plupart du temps, nous préparons des chorégraphies, de beaux tableaux, comme pour Miss France. Il y a des défilés en maillot de bain, par exemple. Nous nous entraînons aussi à la prise de parole au micro, car beaucoup de candidates sont stressées par cet exercice.
Quel genre de questions vous sont posées ?
C'est très varié, cela peut être « Comment voyez-vous Le Havre dans 20 ans ? » ou encore « Que vous évoque la mer au Havre ? ». Il faut montrer que l'on connaît notre ville et que l'on est investi.
Le titre de Miss est-il un atout ?
Je pense que cela nous fait prendre confiance en nous et nous fait grandir. Il faut du courage pour parler devant une assemblée qui scrute tous tes faits et gestes.
Quel métier voudriez-vous faire plus tard ?
Un métier dans le tourisme, parce que j'ai toujours aimé voyager. Je parle l'anglais, un peu l'italien et aime aussi découvrir de nouvelles cultures.
Propos recueillis par Lilou Marie et Emma Paumard, 2GTC
« Forger le mental des Miss est important »
Interview
Naomie Renaud
Miss France 2025 a subi de nombreuses attaques sur Internet, Naomie nous livre son point de vue sur les réseaux sociaux.
Sur quels médias les concours sont-ils diffusés ?
Sur Instagram et Facebook, pour les concours les plus récents comme Miss Le Havre en novembre dernier.
Comment appréhendez-vous la diffusion de l’élection sur les réseaux sociaux ?
Il faut arriver à dépasser ce que peuvent écrire les personnes cachées derrière leur écran et se détacher des représentations. Avoir le courage de se présenter à une élection, c’est déjà énorme. Le plus important est de participer pour soi, pas pour les autres.
Que pensez-vous des attaques subies par Angélique, Miss France 2025, sur Internet ?
Ces attaques sur son origine et sur son âge sont horribles et aberrantes. On a pu lire qu'elle était trop âgée pour une Miss. Au contraire, il me semble que c'est un atout. Casser les codes est important.
Avez-vous déjà rencontré des problèmes liés à la publication sur les réseaux ?
Comme je suis rousse, j’ai parfois eu droit à des commentaires désobligeants sur ma couleur de cheveux. Mais j’ai la chance d’avoir des parents qui m’ont aidée à me forger depuis mon enfance et d’avoir de la répartie pour faire cesser ces moqueries.
Limiter l’usage des réseaux sociaux permettrait-il de pallier ces problèmes ?
Il est difficile de se passer de leur usage car ils permettent aux personnes qui ne peuvent pas se déplacer de suivre l'élection. Il faudrait surtout multiplier les campagnes de prévention, tout en maintenant leur usage.
Avez-vous des idées pour faciliter l’insertion des Miss sur les réseaux ?
Forger le mental des Miss me paraît important.
Pourrait-on en parler au public ?
Des campagnes de sensibilisation dans les écoles permettraient de montrer des images, des articles, ou autres, pour faire prendre conscience de ces dérives et faire évoluer les mentalités.
Propos recueillis par
Anna Jones, 2GTC
« J'ai toujours voulu devenir prof d'EPS »
Interview
Alexandre Bonnet, ancien joueur de football professionnel et professeur d'EPS au lycée Jeanne d'Arc depuis la rentrée 2025.
Pendant combien de temps avez-vous été footballeur professionnel ?
Pendant 19 ans. J'ai commencé ma carrière à Toulouse et ai fait un passage à Sedan, dans les Ardennes, avant d'arrivéer au HAC où je suis resté pendant treize ans. Enfin, j'ai terminé ma carrière à Quevilly Rouen Métropole, il y a deux ans.
Vous avez joué en équipe de France Espoir, avez-vous rencontré des joueurs célèbres ?
En équipe de France, j'ai côtoyé la génération Benzema, Ben Arfa, Gourcuff... Et puis, durant ma carrière, j'ai croisé sur les terrains plein de super joueurs comme Mbappé ou Ribéry.
Pourquoi avoir décidé de devenir ensuite professeur d'EPS ?
C'est un métier que j'ai toujours voulu faire. J'avais déjà repris mes études avant ma retraite de joueur pro pour anticiper cette transition. Et puis, avec une formation supplémentaire, j'ai pu débuter dans ce métier, en commençant par des remplacements.
Que pensez-vous de votre métier de professeur d’EPS au lycée Jeanne d'Arc ?
J'ai été hyper bien accueilli par tous les collègues, notamment par l'équipe EPS qui m'épaule énormément. Cela a donc facilité mon intégration. Tout cela me permet de prendre mes marques et de me sentir de mieux en mieux. Je suis ravi d'être dans cet établissement.
Est-ce qu'il y a des choses qui vous ont surpris ?
Oui, la motivation des élèves que je trouve parfois très faible en sport. Connaissant les bienfaits du sport et de ses valeurs, je trouve cela dommage. Mais c'est aussi à nous, profs d'EPS, de faire en sorte de les stimuler et de leur transmettre le goût de l'effort.
Avez-vous des projets dans votre nouveau métier ?
Continuer à progresser, à me former. Et puis obtenir le concours pour devenir titulaire et ainsi m'installer durablement dans un établissement où je me sentirai épanoui.
Quels conseils donneriez-vous à des élèves qui aimeraient devenir sportifs professionnels ?
Il faut s'accrocher à ses rêves, croire en soi, se faire confiance. Et ensuite, se donner les moyens de réaliser son objectif. Cela passe parfois par des sacrifices, parfois par de belles rencontres. Mais en tout cas, il faut faire en sorte de ne pas avoir de regrets.
Propos recueillis par
Clara Dalifard, Clara Agoutin
et Manon Hébert, 2GTE
« Stranger Things », end of the beginning
L’ultime saison de « Stranger Things » a été dévoilée sur Netflix entre le 27 novembre et le 31 décembre 2025. Clap de fin sur une série qui a marqué la pop culture mondiale.
Cette cinquième et dernière saison comprend huit épisodes d’environ une heure. Sa diffusion s’est échelonnée sur plusieurs semaines : quatre épisodes le 27 novembre, deux épisodes le 26 décembre et le grand final (épisode 8) le 31 décembre, qui dure 2h08.
"Stranger Things" est une série américaine créée en 2016 par les frères Duffer, très imprégnée par l’esthétisme et la musique des années 80. On y suit les aventures d’un groupe d’enfants : Mike, Will, Dustin et Lucas. Un jour, Will va disparaître dans la forêt. Le groupe d’amis part à sa recherche. Au lieu de le retrouver, ils rencontrent Onze, une fille perdue dans la forêt.
Dans la saison 1, on découvre que Onze a des pouvoirs de télékinésie et que Will est coincé dans un univers parallèle peuplé de monstres : Le Monde à l’envers.
Au fur à mesure des saisons, nous découvrons d’autres personnages importants, parmi lesquels Max, Billy et Eddie, ainsi que le principal antagoniste de la série : Vecna.
Un final tragique
La saison 5 est la plus dramatique et déprimante de la série. Sur un plan technique, on peut observer que les effets spéciaux employés rendent les monstres plus crédibles et plus effrayants que jamais. Le Monde à l’envers occupe une place plus importante qu’auparavant, rendant l’atmosphère plus violente et anxiogène. De nouvelles intrigues font leur apparition et un gros plot twist (rebondissement / retournement de situation) attend les spectateurs.
Pour rendre hommage à la série, Netflix a mis en ligne, le 12 janvier, un reportage de deux heures qui présente les coulisses du tournage de la saison 5. On y retrouve les acteurs, les frères Duffer, les équipes techniques, les décors etc. Une belle manière de prolonger le plaisir avant que le rideau ne tombe définitivement sur l’univers de "Stranger Things".
Notre avis
Cette dernière saison est pour nous très émouvante. Nous avons adoré la regarder jusqu’au bout, malgré certaines facilités scénaristiques. Nous estimons notamment que le dernier combat est trop court (cinq minutes seulement) et qu'il a laissé beaucoup de fans complètement dévastés suite au sacrifice d'un des personnages.
Lola Bazire, 2GTA,
Laure Thorel, 1AEPA
et Wallerand Michelet, 1STL
Initiation ludique au Flag football
Lundi 19 janvier, de 10h à midi, Matthieu Odièvre, entraîneur du club de Flag football des Seahawks d’Octeville-sur-Mer, est venu sur le site de Gaulle initier à son sport les 2GTA, dans le cadre du cours d’EPS.
Après avoir présenté aux élèves les grands principes du Flag Football, sport encore méconnu en France (lire notre article dans le JDA n° 28, page 10), Matthieu Odièvre a proposé un échauffement à base de « déflagage ». Le déflagage consiste à essayer de s’emparer d’un des deux drapeaux que les joueurs portent à la ceinture.
La séance s’est poursuivie par des exercices d'esquive, de lancer et de rattrapage du ballon ovale.
Afin de prolonger le plaisir de cette initiation, Matthieu Odièvre a proposé aux élèves intéressés d’assister à l’un des entraînements des Seahawks qui se déroulent le jeudi, de 18h à 19h30, sur le terrain synthétique d’Octeville.
Romain Renouvin, 2GTA
« Prendre soin de soi avant de prendre soin des autres »
Interview - Céline Hecquet, professeure d'EPS et initiatrice du projet Sport et bien-être.
Qu'est-ce que le projet "Sport et bien-être" ?
Ce projet concerne les élèves de première ASSPA (accompagnement, soins et services à la personne) et qui existe depuis trois ans maintenant. On l'a mis en place parce que les élèves de cette filière avaient un taux d'absentéisme important en EPS et beaucoup de dispenses. Or, ce sont des élèves qui vont travailler dans des EHPAD (établissements d'hébergement pour personnes âgées dépendantes), et qui vont donc être amenées, par exemple, à porter des personnes âgées. Ils leur faut préserver leur corps, muscler leur dos. Avant de prendre soin des autres, il faut aussi savoir prendre soin de soi.
L'objectif est de proposer à des élèves, pas forcément très sportives à la base, de pratiquer une activité sportive et de bien-être.
En quoi consistent les activités ?
Les élèves doivent effectuer 15 heures de pratiques sportives ou de bien-être, en plus de leurs heures d'EPS. En début d'année, j'ai présenté aux élèves les différents ateliers auxquels s'inscrire.
Parmi ces activités, nous proposons "pilates", avec Françoise Donneau, et "marche nordique", avec Amélie Aubert, mes collègues d'EPS. J'ai également proposé de la Zumba, ainsi qu'une initiation au golf, au yoga tonique et au fit boxing.
En ce qui concerne l'aspect "bien-être", je propose une séance de sophrologie, une séance de modelage des mains, ainsi qu'une séance de maquillage. Les élèves ont adoré la séance maquillage !
Il est important de souligner que les séances de modelage des mains et de maquillage se font en partenariat avec les élèves du bac Pro et de BTS MECP du site Coty (voir les articles des pages 4 et 5).
Propos recueillis par
Clara Dalifard
et Alice Debieu, 2GTE
Le cyclisme dans la peau
Pauline Ferrand-Prévot, née en 1992 à Reims, est une coureuse cycliste française très complète : elle a remporté de nombreux titres en cyclisme sur route, cyclocross, gravel et VTT cross-country.
Le 27 septembre 2014, Pauline Ferrand-Prévot devient championne du monde sur route pour la première fois. De nombreux titres suivront tout au long de sa longue et riche carrière : championne du monde de cyclo-cross en 2015, cinq fois championne du monde de VTT, championne du monde de gravel en 2022 et gagnante du Tour de France Femmes en 2025. Mais de son propre aveu, sa plus belle victoire demeurera, quoi qu'il arrive, son titre de championne olympique de VTT cross-country en 2024 à Paris.
De nouvelles ambitions
Avec une carrière si accomplie, Pauline Ferrand-Prévot pourrait se reposer sur ses lauriers. Pourtant, ce ne sera pas le cas. La championne annonce ses ambitions pour 2026 : le Tour de France et surtout le Tour des Flandres et le Liège-Bastogne-Liège, deux compétitions qui ne figurent pas encore dans son prestigieux palmarès.
Romain Renouvin, 2GTA